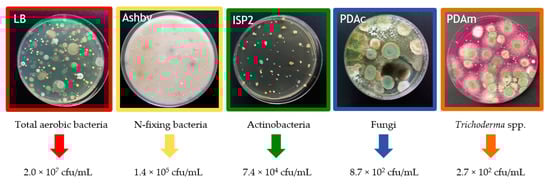

Abstract
Compost teas (CTs) are organic solutions that constitute an interesting option for sustainable agriculture. Those that come from garden waste have been applied in vitro and in vivo on pepper plants to determine its suppressive effect against both Phytophthora capsici and Rhizoctonia solani. The studied CT showed relevant content in NO3−, K2O, humic acids, and microorganisms such as aerobic bacteria, N-fixing bacteria, and actinobacteria, which play a role in plant growth and resistance. This rich abundance of microbiota in the CT induced a reduction in the relative growth rate of both P. capsici and R. solani (31.7% and 38.0%, respectively) in in vitro assays compared to control. In addition, CT-irrigated plants displayed increased growth parameters and showed the first open flower one week before those treatments without CTs, which suggests that its application advanced the crop cycle. Concerning pathogen infection, damage caused by both pathogens became more apparent with a one-week inoculation compared to a four-week inoculation, which may indicate that a microbiological and chemical balance had been reached to cope with biotic stresses. Based on these results, we conclude that CT application induces plant growth and defense in pepper plants against P. capsici and R. solani because of its relevant soluble nutrient content and microbiota richness, which provides a novel point for plant nutrition and protection in horticultural crops.
1. Introduction
Large amounts of bio-waste produced every year and should be managed and valorized to provide a well-humified material employable in agriculture. Therefore, recycling organic waste as organic fertilizer is a relevant strategy for sustainable crop production. The application of these fertilizers to the soil could be applied as compost, green manure, farm yard manure, or cereal residues. Some of this biowaste-biosolids, pruning residues, green waste, sewage sludge-displayed good results when properly composted. []. This material is obtained through composting, a controlled bioxidative process that requires proper humidity, aeration, and heterogeneous solid organic substrates []. Moreover, taking into account the high variability of the parameters that characterize the different composts (pH, electrical conductivity, C-to-N ratio and nutrient content), it is necessary to know their physicochemical and biological properties when applying them to soil or substrate []. Nevertheless, compost is a source of macro- and micronutrients not only for plants but also for the microorganisms that support soil health by serving as a quick and easily available source of carbon [].
Compost from green waste seems to present a lower risk of toxicity than do organic ones, which contain different compounds or microorganisms such as heavy metals, pollutants, viruses, or fecal coliforms [,]. In addition, several authors have shown the stimulant and suppressive effect of different compost applications in many cropping systems against several pathogens such as Fusarium oxysporum, Verticillium dahliae, and Rhizoctonia solani [,].
Moreover, compost teas (CTs) are organic liquid products that come from the mixture of mature compost with tap water in 1:5 or 1:10 (v/v) ratios for a specific period of incubation [,]. Several factors affect CT quality, such as the compost type, compost-to-water ratio, and aeration, which altogether modulate the development of beneficial microorganisms [,,]. Furthermore, CTs are composed of soluble nutrients, and useful compounds and microorganisms (bacteria, actinomycetes, filamentous fungi, oomycetes, and yeasts) that have a synergic effect on suppressing disease and promoting plant growth [,,]. Soluble nutrients, plant-growth regulators, and humic acids have been previously described as mediators in plant disease suppression [,]. Nevertheless, several authors have noted that among the most abundant microorganisms in these extracts are plant-growth promoting rhizobacteria (PGPR), which influence plant growth through different mechanisms (e.g., nitrogen fixation, nutrient solubilization, growth hormones release, and enzymes) that produce a better nutrient availability []. These mechanisms seem to be involved in plant-induced resistance, making plants able to cope with subsequent stresses []. In short, CTs from green waste seem to display the best suppressive effects against a wide range of different plant disease pathogens []. For this reason, the employment of these extracts as a potential eco-friendly alternative to fertilizers and synthetic fungicides has been rising in recent years due to their beneficial effects on crops [,,], but further research is still required.
Pepper (Capsicum annuum L.) is an important horticultural crop worldwide for its nutritional and medicinal value, and has an annual production of more than 38,000,000 tons [,]. The pepper fruit is widely consumed for its richness in vitamins, minerals, and nutrients, as well as in phytochemicals like carotenoids, capsaicinoids, flavonoids, ascorbic acid, and tocopherols []. Moreover, pepper production could be compromised by different soilborne pathogens such as Phytophthora capsici and Rhizoctonia solani. P. capsici, one of the most economically destructive soil-borne pathogens, causes root rot and foliar, stem and fruit blight of the pepper plant []. Moreover, the fungus R. solani can also produce seed decay, pre- and post-emergence damping-off, wire stem, leaf decay, root rot, and hypocotyl or taproot with necrotic spots on the pepper [,]. The trend towards increasingly organic agriculture has resulted in the need to find new enviro-friendly compounds to control plant diseases. In this context, we hypothesized that the application of a nutrient- and microbial-rich CT obtained from green waste mature compost would improve plant growth and mediate plant defenses. Thus, the main objective of this work was to determine the bio-stimulant and suppressive effect of the extract against P. capsici and R. solani soil-borne pathogens.
2. Materials and Methods
2.1. Compost Tea Preparation
The compost tea (CT) came from the composting of green and pruning wastes carried out in a garden center located in Salamanca (Spain) (40°57′23″ N; 5°41′8″ W, 775 m a.s.l.). This process was performed in aerated piles of 15 × 2 × 2 m for 180 days. Piles were turned twice per week for eight weeks and once a week during the rest of the bio-oxidative process. Moreover, the moisture of the piles was controlled once a week. The mature compost was obtained under ambient conditions in March. Then, compost was mixed with tap water in a ratio of 1:5 (v/v) in polyethylene non-degradable 1000 L containers at room temperature for a brewing period lasting five days. Water had been previously aerated for 8 h to reduce the number of chlorines. This mixture was aerated for five hours every day with a pump. Then, it was filtered with a double-layered cheesecloth, and the aerated CT was stored in a dark container until use.
2.2. Chemical and Microbiological Properties of the Compost Tea
The chemical properties of 9 CT samples were directly analyzed. The pH, electrical conductivity (EC) and C-to-N ratio were determined as described by Morales-Corts et al. []. Furthermore, assimilable nutrient contents (NO3−, PO43−, K2O, SO42−, Ca2+ and Mg2+) were analyzed with the nutrient analysis photometer HANNA HI 83225. Finally, humic acids were determined following the alkali-acid method described by Pant et al. [].
Microbial analysis of the CT was estimated using the serial dilution spread plate method. To determine the microbial population, different selective culture media and CT dilutions were used for microorganism isolation: nutrient agar and 10−3 dilution for total aerobic bacteria, Ashby medium, and 10−2 dilution for N-fixing bacteria, ISP-2 medium and 10−1 dilution for actinobacteria and modified potato dextrose agar medium but no dilution for total fungi and Trichoderma ssp. quantification [,,,]. Then, plates were inoculated by depositing on the agar surface 0.1 mL of the CT dilution, which was spread on the media surface with sterile glass beads. Moreover, non-inoculated plates were included as a negative control. Petri dishes were incubated in the dark at 28 °C for 3 to 15 days, depending on the medium. After this time, colony-forming units (CFU) were counted to estimate the cultivable microorganism’s population. This experiment was conducted using five replications.
2.3. In Vitro Assays
An initial in vitro test was performed to determine the suppressive effect of the CT against the pathogens R. solani and P. capsici. The relative growth of both pathogens was measured in Petri dishes of 90 mm in diameter, prepared with sterilized PDA at 60 °C with the CT added after sterilization. Once the medium solidified, a 5-mm diameter PDA plug of R. solani or P. capsici was inserted into the center of the Petri plates. The CT-to-PDA relation was 1:10. Furthermore, controls of each strain were included in sterilized water and a PDA medium to assess their growth in the absence of the CT. The growth diameter of the pathogens (mm) was assessed at seven days after inoculation. In the end, the RGR was calculated (relative growth rate of the pathogen in comparison to the growth of the colony without the CT) []. The essay was carried out including five replications per treatment. Petri dishes were maintained in the dark at 24 °C for 7 days. This experiment was repeated three times. The P. capsici strain proceeded from a selection of Neiker (Basque Center of Agricultural Research) and Rhizoctonia solani strain from the pathogen collection of the Regional Center for Pest and Diseases Diagnosis, Junta de Castilla y León.
2.4. In Vivo Assays
For in vivo assays, on May 3, pepper seeds (Capsicum annuum cv. Morrón de Conserva 4) were germinated in a sterile substrate formed by vermiculite. When the plants had four leaves (30 days after sowing), they were transferred to 15 × 12 × 15 cm pots containing a sterile mix of blond peat (50%), sandy, acid pH, and nutrient-poor soil (37.5%, from Ledesma-Salamanca) and vermiculite (12.5%) as a very nutritive-deficient substrate. The main characteristics of the substrate were: pH 6, 70 mg L−1 N, 71 mg L−1 P2O5, 150 mg L−1 K2O, 35% of organic matter, 0.6 dS m−1 EC.
The experiment was carried out in a greenhouse under the following conditions: temperature 24 °C day, 18 °C night and 80% relative humidity. Ten different treatments were considered depending on the CT supply (40 mL was supplied weekly and individually by irrigation), pathogen inoculation, and inoculation time: T1 (CT), T2 (CT + R. solani inoculation one week after transplanting), T3 (CT + P. capsici inoculation one week after transplanting), T4 (Control plants inoculated with R. solani one week after transplanting), T5 (Control plants inoculated with P. capsici one week after transplanting), T6 (CT + R. solani inoculation four weeks after transplanting), T7 (CT + P. capsici inoculation four weeks after transplanting), T8 (Control plants inoculated with R. solani four weeks after transplanting), T9 (Control plants inoculated with P. capsici four weeks after transplanting) and T10 (Control plants without infection) (Figure 1). For pathogen inoculation, the rice grain method was carried out []. Six inoculated rice seeds were placed per pot. Moreover, to determine the effect of CT application, the following plant growth and production parameters were determined: stem diameter measured with a digital caliper, chlorophyll content with a chlorophyll meter Minolta SPAD-502 (both were measured at mid-cycle), dry weight of the root system, and an aerial part (before being weighed, the plants were dried in a P-Selecta-210 oven at 65 °C for 48 h), flowering date, fruit weight, and amount of fruit per plant. The total dry biomass produced per plant was calculated as the sum of the dry fruit, root, and aerial parts. Weights were determined by using a precise balance Sartorius BL150S. Furthermore, the pathogen incidence was also determined following a specific symptom scale (1–5). The experimental design was a randomized complete-block design with eight plants per treatment. This essay was carried out twice during 2017 and 2018.

Figure 1.
Summary of treatments.
2.5. Statistical Analyses
Statistical analyses were carried out by one-way analysis of variance in Statgraphics Centurion XVIII software (Statistical Graphics Corp., Rockville, MD, USA). Results were presented as means with standard errors, and for comparison the Tukey’s Honest Significant Difference (HSD) test with a 95% confidence interval (p < 0.05) was used.
3. Results
3.1. Compost Tea Properties
The studied characteristics (pH, EC, C-to-N ratio, assimilable macro and micronutrients, and humic acids) are shown in Table 1. Highlighted are the high NO3− and K2O concentrations (2240.4 and 2851.2 ppm, respectively) and the low C-to-N ratio of the extract, as well as the relevant humic acids amount

Table 1.
Chemical characteristics of the studied CT. Results are indicated as mean ± standard deviation.
Concerning the microbiological analysis of the CT, the most abundant group of microorganisms was total aerobic bacteria followed by the N-fixing bacteria and actinobacteria (Figure 2). Moreover, Trichoderma spp. and fungi were found between 2.7 and 8.7 × 102 cfu/mL, respectively.
Figure 2.
Microbial populations in green waste compost tea.
3.2. Compost Tea Effect in In Vitro Assays against Rhizoctonia solani and Phytophthora capsici
To study in vitro growth of the plant pathogens R. solani and P. capsici in response to application of the CT, the relative growth rate of each pathogen was calculated. According to this parameter, the relative growth rates of both R. solani and P. capsici pathogens were 38% and 31.7%, respectively, in comparison to the control treatment (Figure 3 and Table 2).

Figure 3.
Effect of CT on the relative growth rate of R. solani and P. capsici in comparison to control treatment.

Table 2.
Relative growth rate of R. solani and P. capsici in CT treatment. Results are indicated as mean ± standard deviation.
3.3. Compost Tea Effect in In Vivo Assays against Rhizoctonia solani and Phytophthora capsici
As shown in Table 3, the treatments with compost tea (T1, T2, T3, T6 and T7) advanced the flowering date of pepper plants. CT treatment (T1) also produced an increase in the diameter of the stem in comparison to the control (T10). Likewise, the measurement of this parameter also indicated significant differences in T6 and T7 (CT + R. solani or P. capsici inoculation four weeks after transplanting) compared to T10. On the other hand, although there were no significant differences, those treatments inoculated with R. solani and P. capsici one week after transplanting (T4 and T5) showed lower means than the control did for diameter and chlorophyll content parameters.

Table 3.
Plant growth parameters of pepper plants grown under the different treatments.
To examine whether the observed changes in growth were related to the CT application and R. solani and P. capsici diseases, the total amount of fruits, plant dry weight, and pathogen incidence were measured (Table 4). Plants irrigated with the CT (T1) displayed the best results in the total weight of pepper fruit, being two times higher than those of T10. Moreover, CT-treated and -inoculated treatments (T2, T3, T7, and T8) slightly improved the aerial biomass parameters compared to the control (without significant differences). Plants inoculated with R. solani or P. capsici one week after transplanting (T4 and T5) showed a reduction in shoot and root dry weight, while plants of T5 also presented a decrease in total fruit weight.

Table 4.
Fruit production, plant dry weight and R. solani and P. capsici incidence on pepper plants under CT application.
Concerning pathogen incidence, it should be pointed out that collapse only occurred in one plant of the T5 treatment. Furthermore, most of the treatment plants showed different symptoms such as black roots, narrow neck, and a thin stem (grade 3 attack severity) and those plants of T4 displayed a grade 2 pathogen attack. Moreover, T8 and T9 (R.solani and P.capsici inoculated 4 weeks after transplanting) generated less damage than inoculations a week after transplanting (T4 and T5) considering the damage severity of grade 1 and 2, respectively. In addition, it should be noted that there were significant differences among the inoculated P. capsici plants one week after transplanting under CT and control conditions (T3 and T5, respectively). Furthermore, there were no differences between CT-treated and inoculated with R. solani plants one week after transplanting (T2) and those treated and inoculated four weeks after transplanting (T6), while there were significant differences between T2 and T4.
The total dry biomass produced per plant and treatment are shown in Figure 4. Treatments with the CT (T1, T2, T3, T6, and T7) increased the total biomass of plants. This effect was significant when CT (T1) and control without CT application (T10), were compared. The CT application produced an 36% increase in biomass over control. Plants inoculated with P. capsici one week after transplanting (T5) displayed a 50% reduction in biomass production with respect to those inoculated and treated with the CT (T3).

Figure 4.
Total dry biomass produced per pepper plant and treatment. T1: CT (compost tea); T2 and T3: CT + pathogen inoculated one week after transplanting; T4 and T5: pathogen inoculated one week after transplanting; T6 and T7: CT + pathogen inoculated four weeks after transplanting; T8 and T9: pathogen inoculated four weeks after transplanting; T10: control. Different letters above the columns indicate significant differences (p < 0.05).
4. Discussion
The present work showed that green waste CT not only promotes plant development, but also protects plants when exposed to R. solani and P. capsici pathogens at different times from transplanting.
In this study, a CT coming from green waste was tested. First, the chemical properties of this extract were studied, and the results showed that not only did the CT dose play a relevant role in plant growth and plant resistance, but it also improved soil quality [,]. The pH and EC were significantly lower than those obtained by other authors [,]. The result of the C-to-N ratio showed a reduction with respect to the original compost (11.4) [], which indicated a low C amount in relation to the N extracted in the CT. This low ratio points to the extract’s high stability and conservation. Nutrient analyses revealed that nitrogen (N) and potassium (K) were well presented in this CT, making teas an interesting source of fertilizer for crop application. Furthermore, high K concentration could also be beneficial for plant resistance against both R. solani and P. capsici infections, since Amtmann et al. [] wrote that K application tends to reduce fungal diseases. In addition, the high content of humic acids (10.3% of dry matter) could explain the positive effect of the obtained CT on plant growth promotion and resistance. Besides, the application of humic acids enhances phenolic and flavonoid accumulation and improves yields in Cichorium intybus plants []. Several authors have linked humic substances as compounds having an auxin-like activity that induces nitrate metabolism for plant growth [,]. In addition, Morales-Corts et al. [] explained that the growth effect of CT could be not only explained by humic acid content, but also by nutrient concentration, phytohormones, and the presence of beneficial microorganisms. Therefore, the microbiota in a CT also play a fundamental role in the ability of these extracts to suppress plant diseases or promote growth []. Bacterial communities (total aerobic bacteria and N-fixing bacteria) were the predominant microorganisms in this aerated CT. These results follow Kim et al. [], who observed similar population densities of culturable bacteria in the mixture of oriental medicinal herb compost and vermicompost tea during incubation. Furthermore, Li et al. [] showed analogous results in microbial populations in maize straw CT, having the most total bacteria microbial populations, followed by actinomycetes and total fungi. It is clear that microbial communities found in a CT can be indirectly responsible for growth improvement with respect to the control because of their implication for the availability of nutrients as previously suggested by Hamid et al. [], especially due to K+ content in the studied CT.
Concerning the inhibitory effect of the CT on the studied fungal pathogens, in vitro assay results showed that the application of CT to PDA (1:10) significantly decreased the growth rate of R. solani and P. capsici in comparison with the control treatment. According to these results, Dionne et al. [] showed that the CT significantly reduced the growth of the mycelium of R. solani. This reduction seems to be related to the high microbiota population, since in our experiment the sterilized CT did not show this direct suppressive effect (data not shown). Hence, CT-enriched media displayed a large number of microorganisms that could directly repress fungi growth. In addition to this statement, several authors have previously written that microbial populations are required to determine the suppressive effect of the CT [,]. Moreover, the CT contains different species of the genera Trichoderma, Penicillium, Aspergillus, Bacillus, Enterobacter, Rhizobacteria or Pseudomonas spp., among others, which could have the ability to control pathogens and stimulate plant growth [,,,].
The effect of a CT on plant growth and resistance against P. capsici and R. solani was tested. The plants grown under CT treatment (T1) displayed the best results in biomass and in the total and average weight of fruit. These results are in concordance with those indicated by Ros et al. [], who pointed that the foliar application of CT increases the yield and quality of baby spinach plants. This could be explained by the contribution of nutrient content, humic acids, and microbial population in growth promotion []. In addition to this statement, Reeve et al. [] indicated that the nutrient content in a CT could supplement or substitute for other types of fertilizers.
Moreover, it should be pointed out that the CT application carried out in this trial does not provide all the necessary nutrients for the pepper crop, since the control plants showed nutritional deficiencies from the middle of the cycle. Therefore, a supplementary fertilization is required to cover the nutritional requirements of pepper plants to get a high yield. Therefore, the combination of mineral and organic components should be considered to reduce the chemical resources application. In relation to this statement, several authors tested the combination compost or mineral solubilizing microorganism with fertilizers as a good solution to increase the availability of nutrients [,,].
It is relevant to the point that the first flower of the CT-treated plants (T1, T2, T3, T6, and T7) started opening one week before those without CT treatment (Table 3), which indicates that application of the CT advanced the crop cycle. Similar results were observed in potato plants treated with garden waste CT []. Furthermore, pepper plants inoculated with P. capsici one week after transplanting (T5) showed a reduction in fruit weight as well as in stem and root dry weight compared to the control treatment. These plants also displayed a higher grade of pathogen incidence (black roots, narrow neck, thin stem, leaf decay and very pronounced chlorosis). In addition, plants treated with CT and inoculated with P. capsici (T3 and T7) showed a reduction in pathogen incidence. They increased growth parameters (total fruit weight, average fruit weight, dry weight of the root, and aerial part and total biomass). This fact may be due to the microbial populations of CT since Ezziyyani et al. [] previously revealed that both Trichoderma harzianum and actinobacteria effectively reduce the attack of Phytophthora capsici.
Moreover, regarding the disease produced by R. solani, plants inoculated with this pathogen one week after transplanting (T4) displayed grade 2 pathogen incidence and a reduction in root and stem weight relative to the control. Interestingly, as for P. capsici, plants presented less pathogen damage when inoculated with R. solani four weeks after transplanting (T8) with respect to those inoculated one week after transplanting (T4). This point led us to conclude that CT application had a suppressive effect on the attack of R. solani as shown in in vitro cultures. Moreover, several authors previously studied the effect of different CTs on R. solani control in different plant species [,]. In this line, Morales-Corts et al. [] confirmed the effect of green waste CT on the control of this pathogen in potato plants. This fact is directly related to the presence of Trichoderma spp., among other microbial antagonists and parasitic or antibiotic-producer microorganisms [,], and to indirect mechanisms inducing systemic resistance in plants []. In this sense, the addition of PGPR may enhance auxin production in the rhizosphere which is linked to developing stress tolerance in plants. Consequently, the addition of CT could minimize stress in the pepper plants caused by pathogens, especially when the application is carried out before an attack.
Altogether, indications are that this CT could be considered as a green alternative to supplement, or substitute for, other types of fertilizers and pesticides. Since pepper is one of the most important human food crops, management strategies using CT obtained from green waste (following the Sustainable Development Goals of the United Nations to achieve a better and more sustainable future []) could be relevant in integrated and sustainable agriculture.
5. Conclusions
This study confirmed the positive effect of CT application (based on green waste) on total biomass and pepper fruit production and for its direct implication for the control of pathogen development by causing a reduction of both P. capsici and R. solani in in vitro and in vivo essays. The studied extract presented relevant content in NO3−, K2O, humic acids, and microorganisms, which seem to play a synergic role in plant growth and protection. Microbiota in the CT induced a reduction in the relative growth rate of both P. capsici and R. solani (31.7% and 38.0%, respectively) in in vitro assays compared to the control. Moreover, the effect on pathogen control was significant in P. capsici early attacks in the in vivo assays. The CT application produced a 36% increase in biomass with respect to the control, and plants treated with the CT started flowering one week before those that were not treated, thus indicating that the application of the CT advanced the crop cycle. Despite its bio-stimulant action on plant growth, CT application in this trial did not provide all the necessary nutrients for the pepper crop. Therefore, supplementary fertilization is required to cover the nutritional requirements to obtain a high yield. Further studies should be conducted under field conditions and combined with other fertilizers.
Author Contributions
Conceptualization, M.R.M.-C. and M.B.S.-F.; Methodology, M.R.M.-C., R.P.-S. and M.B.S.-F.; Software, A.I.G.-H., M.Á.G.-S. and M.R.M.-C.; Validation, M.R.M.-C. and A.I.G.-H.; Investigation, M.R.M.-C., M.Á.G.-S., A.I.G.-H., R.P.-S. and M.B.S.-F.; Data Curation, M.R.M.-C., M.Á.G.-S., A.I.G.-H., R.P.-S. and M.B.S.-F.; Writing—Original Draft Preparation, A.I.G.-H. and M.R.M.-C.; Writing—Review & Editing, A.I.G.-H., M.R.M.-C. and R.P.-S.; Project Administration, M.R.M.-C.; Funding Acquisition, M.R.M.-C. All authors have read and agreed to the published version of the manuscript.
Funding
This research was supported by Fertiberia and Salamanca University 83 Contract Agreement (Grow-in inductive fertilization).
Institutional Review Board Statement
Not applicable.
Acknowledgments
The authors thank Neiker (Basque Center of Agricultural Research) for the Phytophthora capsici strain pathogen and to the Regional Center for pest and Diseases Diagnosis, Junta de Castilla y León, Spain for the Rhizoctonia solani strain pathogen.
Conflicts of Interest
The authors declare no conflict of interest.
References
- Zaller, J.G. Vermicompost as a substitute for peat in potting media: Effects on germination, biomass allocation, yields and fruit quality of three tomato varieties. Sci. Hortic. 2007, 112, 191–199. [Google Scholar] [CrossRef]
- Bernal, M.P.; Alburquerque, J.A.; Moral, R. Composting of animal manures and chemical criteria for compost maturity assessment. A review. Bioresour. Technol. 2009, 100, 5444–5453. [Google Scholar] [CrossRef]
- Benito, M.; Masaguer, A.; De Antonio, R.; Moliner, A. Use of pruning waste compost as a component in soilless growing media. Bioresour. Technol. 2005, 96, 597–603. [Google Scholar] [CrossRef]
- Darzi, M.T.; Seyedhadi, M.H.; Rejali, F. Effects of the application of vermicompost and phosphate solubilizing bacterium on the morphological traits and seed yield of anise (Pimpinella anisum L.). J. Med. Plants Res. 2012, 6, 215–219. [Google Scholar]
- Moretti, S.M.L.; Bertoncini, I.B.; Abreu-Junior, C.H. Composting sewage sludge with green waste from tree pruning. Sci. Agric. 2015, 72, 432–439. [Google Scholar] [CrossRef]
- Marin, F.; Santos, M.; Dianez, F.; Carretero, F.; Gea, F.J.; Yau, J.A.; Navarro, M.J. Characters of compost teas from different sources and their suppressive effect on fungal phytopathogens. World J. Microbiol. Biotechnol. 2013, 29, 1371–1381. [Google Scholar] [CrossRef] [PubMed]
- Markakis, E.A.; Fountoulakis, M.S.; Daskalakis, G.C.; Kokkinis, M.; Ligoxigakis, E.K. The suppressive effect of compost amendments on Fusarium oxysporum f.sp. radicis-cucumerinum in cucumber and Verticillium dahliae in eggplant. Crop Prot. 2016, 79, 70–79. [Google Scholar] [CrossRef]
- Al-Dahmani, J.H.; Abbasi, P.A.; Miller, S.A.; Hoitink, H.A.J. Suppression of bacterial spot of tomato with foliar sprays of compost extracts under greenhouse and field conditions. Plant Dis. 2003, 87, 913–919. [Google Scholar] [CrossRef] [PubMed]
- Morales-Corts, M.R.; Pérez-Sánchez, R.; Gómez-Sánchez, M.A. Efficiency of garden waste compost teas on tomato growth and its suppressiveness against soilborne pathogens. Sci. Agric. 2018, 75, 400–409. [Google Scholar] [CrossRef]
- Ingham, E.R. What is compost tea? Part 1. BioCycle 1999, 40, 74–75. [Google Scholar]
- Martin, C.C.G.; Dorinvil, W.; Brathwaite, R.A.I.; Ramsubhag, A. Effects and relationships of compost type, aeration and brewing time on compost tea properties, efficacy against Pythium ultimum, phytotoxicity and potential as a nutrient amendment for seedling production. Biol. Agric. Hortic. 2012, 28, 185–205. [Google Scholar] [CrossRef]
- Mengesha, W.K.; Powel, S.M.; Evans, K.J.; Barry, K.M. Diverse microbial communities in non-aerated compost teas suppress bacterial wilt. World J. Microbiol. Biotechnol. 2017, 33, 49. [Google Scholar] [CrossRef]
- De Corato, U. Agricultural waste recycling in horticultural intensive farming systems by on-farm composting and compost-based tea application improves soil quality and plant health: A review under the perspective of a circular economy. Sci Total Environ. 2020, 738, 139840. [Google Scholar] [CrossRef] [PubMed]
- Zaccardelli, M.; Sorrentino, R.; Caputo, M.; Scotti, R.; De Falco, E.; Pane, C. Stepwise-Selected Bacillus amyloliquefaciens and B. subtilis Strains from Composted Aromatic Plant Waste Able to Control Soil-Borne Diseases. Agriculture 2020, 10, 30. [Google Scholar] [CrossRef]
- Castano, R.; Borrero, C.; Aviles, M. Organic matter fractions by SP-MAS 13C NMR and microbial communities involved in the suppression of Fusarium wilt in organic growth media. Biol. Control 2011, 58, 286–293. [Google Scholar] [CrossRef]
- Siddiqui, Y.; Sariah, M.; Ismail, M.R.; Asgar, A. Trichoderma-fortified compost extracts for the control of Choanephora wet rot in okra production. Crop Prot. 2008, 27, 385–390. [Google Scholar] [CrossRef]
- Pant, A.P.; Radovich, T.J.; Hue, N.V.; Paull, R.E. Biochemical properties of compost tea associated with compost quality and effects on pak choi growth. Sci. Hortic. 2012, 148, 138–146. [Google Scholar] [CrossRef]
- Ilangumaran, G.; Smith, D.L. Plant growth promoting rhizobacteria in amelioration of salinity stress: A systems biology perspective. Front. Plant Sci. 2017, 8, 1768. [Google Scholar] [CrossRef]
- Hamid, S.; Ahmad, I.; Akhtar, M.J.; Iqbal, M.N.; Shakir, M.; Tahir, M.; Rasool, A.; Sattar, A.; Khalid, M.; Ditta, A.; et al. Bacillus subtilis Y16 and biogas slurry enhanced potassium to sodium ratio and physiology of sunflower (Helianthus annuus L.) to mitigate salt stress. Environ. Sci. Pollut Res. Int. 2021. Online ahead of print. [Google Scholar] [CrossRef]
- Martin, C.C.S. Potential of compost tea for suppressing plant diseases. CAB Rev. 2014, 9, 1–38. [Google Scholar]
- Pane, C.; Celano, G.; Villecco, D.; Zaccardelli, M. Control of Botrytis cinerea, Alternaria alternata and Pyrenochaeta lycopersici on tomato with whey compost-tea applications. Crop Prot. 2012, 38, 80–86. [Google Scholar] [CrossRef]
- Shaban, H.; Fazeli-Nasab, B. An Overview of the Benefits of Compost tea on Plant and Soil Structure. Adv. Biores. 2015, 6, 154–158. [Google Scholar]
- Food and Agriculture Organization (FAO). Faostat: Agriculture Data. 2019. Available online: http://www.fao.org/faostat/en/#data/QC/visualize (accessed on 5 December 2020).
- Sundaramoorthy, S.; Raguchander, T.; Ragupathi, N.; Samiyappan, R. Combinatorial effect of endophytic and plant growth promoting rhizobacteria against wilt disease of Capsicum annuum L. caused by Fusarium Solani. Biol. Control 2012, 60, 59–67. [Google Scholar]
- Kim, E.H.; Lee, S.Y.; Baek, D.Y.; Park, S.Y.; Lee, S.G.; Ryu, T.H.; Lee, S.K.; Kang, H.J.; Kwon, O.H.; Kil, M.; et al. A comparison of the nutrient composition and statistical profile in red pepper fruits (Capsicums annuum L.) based on genetic and environmental factors. Appl. Biol. Chem. 2019, 62, 48. [Google Scholar] [CrossRef]
- Barchenger, D.W.; Lamour, K.H.; Bosland, P.W. Challenges and Strategies for Breeding Resistance in Capsicum annuum to the Multifarious Pathogen, Phytophthora Capsici. Front Plant Sci. 2018, 9, 628. [Google Scholar] [CrossRef]
- Sherf, A.F.; MacNab, A.A. Vegetable Diseases and Their Control, 2nd ed.; Wiley: New York, NY, USA, 1986; pp. 334–337. [Google Scholar]
- Mannai, S.; Jabnoun-Khiareddine, H.; Nasraoui, B.; Daami-Remadi, M. Rhizoctonia Root Rot of Pepper (Capsicum annuum): Comparative Pathogenicity of Causal Agent and Biocontrol Attempt using Fungal and Bacterial Agents. J. Plant Pathol. Microbiol. 2018, 9, 1000431. [Google Scholar]
- Morales-Corts, M.R.; Gómez-Sánchez, M.A.; Pérez-Sánchez, R. Evaluation of green/pruning wastes compost and vermicompost, slumgum compost and their mixes as growing media for horticultural production. Sci. Hortic. 2014, 172, 155–160. [Google Scholar] [CrossRef]
- Wickerham, L.J. Taxonomy of yeasts. U.S. Dept. Agric. Tech. Bull. 1951, 1029, 1–56. [Google Scholar]
- Sanchis Solera, J. Comparación entre los diversos medios de cultivo comerciales para aislamiento de hongos (levaduras y mohos). In Proyecto Microkit 1999 Para Optimizar la Sensibilidad de los Parámetros de Muestras Microbiológicos del aire; Laboratorios Microkit, S.L.: Madrid, Spain, 1996. [Google Scholar]
- Stella, M.; Suhaimi, M. Selection of suitable growth medium for free-living diazotrophs isolated from compost. J. Trop. Agric. Fd. Sc. 2010, 38, 211–219. [Google Scholar]
- Vargas-Gil, S.; Pastor, S.; March, G.J. Quantitative isolation of biocontrol agents Trichoderma spp., Gliocladium spp. and actinomycetes from soil with culture media. Microbiol. Res. 2006, 164, 196–205. [Google Scholar] [CrossRef]
- Köller, W.; Wilcox, W.F. Evidence for the predisposition of fungicide-resistant isolates of venturia inaequalis to a preferential selection for resistance to other fungicides. Phytopathology 2001, 91, 776–781. [Google Scholar] [CrossRef] [PubMed]
- Holmes, K.A.; Benson, D.M. Evaluation of Phytophthora parasitica var. nicotianae for biocontrol of Phytophthora parasitica on Cathar. Roseus. Plant Dis. 1994, 78, 193–199. [Google Scholar] [CrossRef]
- Scheuerell, S.J.; Mahaffee, W.F. Compost tea as a container medium drench for suppressing seedling damping-off caused by Pythium ultimum. Phytopathology 2004, 94, 1156–1163. [Google Scholar] [CrossRef]
- Siddiqui, Y.; Meon, S.; Ismai, R.; Rahmani, M. Bio-potential of compost tea from agro-waste to suppress Choanephora cucurbitarum L. the causal pathogen of wet rot of okra. Biol. Control 2009, 49, 38–44. [Google Scholar] [CrossRef]
- Naidu, Y.; Meon, S.; Kadir, J.; Siddiqui, Y. Microbial starter for the enhancement of biological activity of compost tea. Int. J. Agric Biol. 2010, 12, 51–56. [Google Scholar]
- Amtmann, A.; Troufflard, S.; Armengaud, P. The effect of potassium nutrition on pest and disease resistance in plants. Physiol. Plant. 2008, 133, 682–691. [Google Scholar] [CrossRef]
- Gholami, H.; Saharkhiz, M.J.; Fard, F.R.; Ghani, A.; Nadaf, F. Humic acid and vermicompost increased bioactive components, antioxidant activity and herb yield of Chicory (Cichorium intybus L.). Biocatal. Agric. Biotechnol. 2018, 14, 286–292. [Google Scholar] [CrossRef]
- Eyheraguibel, B.; Silvestre, J.; Morard, P. Effects of humic substances derived from organic waste enhancement on the growth and mineral nutrition of maize. Bioresour Technol. 2008, 99, 4206–4212. [Google Scholar] [CrossRef]
- Muscolo, A.; Sidari, M. Carboxyl and phenolic humic fractions affect callus growth and metabolism. Soil Sci. Soc. Am. J. 2009, 73, 1119–1129. [Google Scholar] [CrossRef]
- Kim, M.J.; Shim, C.K.; Kim, Y.K.; Hong, S.J.; Park, J.H.; Han, E.J.; Kim, J.H.; Kim, S.C. Effect of Aerated Compost Tea on the Growth Promotion of Lettuce, Soybean, and Sweet Corn in Organic Cultivation. Plant Pathol. J. 2015, 31, 259–268. [Google Scholar] [CrossRef]
- Li, X.; Wang, X.; Shi, X.; Wang, Q.; Li, X.; Zhang, S. Compost tea-mediated induction of resistance in biocontrol of strawberry Verticillium wilt. J. Plant Dis. Prot. 2020, 127, 257–268. [Google Scholar] [CrossRef]
- Dionne, A.; Tweddell, R.J.; Antoun, H.; Avis, T.J. Effect of non-aerated compost teas on damping-off pathogens of tomato. Can. J. Plant Pathol. 2012, 34, 51–57. [Google Scholar] [CrossRef]
- Diánez, F.; Santos, M.; Tello, J.C. Suppressive effects of grape marc compost on phytopathogenic oomycetes. Arch. Phytopathol. Plant Prot. 2007, 40, 1–18. [Google Scholar] [CrossRef]
- Phae, C.G.; Shoda, M. Expression of the suppresive effects of Bacillus sibtilis on phytopathogens in inoculated compost. J. Ferment Bioeng 1990, 70, 409–414. [Google Scholar] [CrossRef]
- Scheuerell, S.J.; Mahaffee, W.F. Compost Tea: Principles and Prospects for Plant Disease Control. Compost. Sci. Util. 2002, 10, 313–338. [Google Scholar] [CrossRef]
- Sylvia, E.W. The effect of compost extract on the yield of strawberries and severity of Botrytis Cinerea. J. Sustain Agr. 2004, 25, 57–68. [Google Scholar]
- Ingham, E.R. The Compost Tea Brewing Manual, 5th ed.; Soil Food International Inc.: Corvallis, OR, USA, 2005. [Google Scholar]
- Ros, M.; Hurtado-Navarro, M.; Giménez, A.; Fernández, J.A.; Egea-Gilabert, C.; Lozano-Pastor, P.; Pascual, J.A. Spraying Agro-Industrial Compost Tea on Baby Spinach Crops: Evaluation of Yield, Plant Quality and Soil Health in Field Experiments. Agronomy 2020, 10, 440. [Google Scholar] [CrossRef]
- Marín, F.; Diánez, F.; Santos, M.; Carretero, F.; Gea, F.J.; Castañeda, C.; Navarro, M.J.; Yau, J.A. Control of Phytophthora capsici and Phytophthora parasitica on pepper (Capsicum annuum L.) with compost teas form different sources, and their effects on plant growth promotion. Phytopathol. Mediterr. 2014, 53, 216–228. [Google Scholar]
- Reeve, J.R.; Carpenter-Boggs, L.; Reganold, J.P.; York, A.L.; Brinton, W.F. Influence of biodynamic preparations on compost development and resultant compost extracts on wheat seedling growth. Bioresour. Technol. 2010, 101, 5658–5666. [Google Scholar] [CrossRef]
- Ditta, A.; Imtiaz, M.; Mehmood, S.; Rizwan, M.S.; Mubeen, F.; Aziz, O.; Qian, Z.; Ijaz, R.; Tu, S. Rock phosphate enriched organic fertilizer with phosphate solubilizing microorganisms improves nodulation, growth and yield of legumes. Comm. Soil Sci. Plant Anal 2018, 49, 2715–2725. [Google Scholar] [CrossRef]
- Ditta, A.; Muhammad, J.; Imtiaz, M.; Mehmood, S.; Qian, Z.; Tu, S. Application of rock phosphate enriched composts increases nodulation, growth and yield of chickpea. Int. J. Recycl. Org. Waste Agric. 2018, 7, 33–40. [Google Scholar] [CrossRef]
- Hussain, A.; Zahir, Z.A.; Ditta, A.; Tahir, M.U.; Ahmad, M.; Mumtaz, M.Z.; Hayat, K.; Hussain, S. Production and Implication of Bio-Activated Organic Fertilizer Enriched with Zinc-Solubilizing Bacteria to Boost up Maize (Zea mays L.) Production and Biofortification under Two Cropping Seasons. Agronomy 2020, 10, 39. [Google Scholar] [CrossRef]
- López-Martín, J.J.; Morales-Corts, M.R.; Pérez-Sánchez, R.; Gómez-Sánchez, M.A. Efficiency of garden waste compost teas on potato growth and its suppressiveness against Rhizoctonia. Agric. For. 2018, 64, 7–14. [Google Scholar]
- Ezziyyani, M.; Requena, M.E.; Pérez-Sánchez, C.; Candela, M.E. Efecto del sustrato y la temperatura en el control biológico de Phytophthora capsici en pimiento (Capsicum annuum L.). An. de Biol. 2005, 27, 119–126. [Google Scholar]
- Tateda, M.; Yoneda, D.; Sato, Y. Effects of Compost Tea Making from Differently Treated Compost on Plant Disease Control. J. Wetl. Res. 2007, 9, 91–98. [Google Scholar]
- Pane, C.; Piccolo, A.; Spaccini, R.; Celano, G.; Villecco, D.; Zaccardelli, M. Agricultural waste-based composts exhibiting suppressivity to diseases caused by the phytopathogenic soil-borne fungi Rhizoctonia solani and Sclerotinia minor. Appl. Soil Ecol. 2013, 65, 43–51. [Google Scholar] [CrossRef]
- Krause, M.S.; Madden, L.V.; Hoitink, H.A.J. Effect of potting mix microbial carrying capacity on biological control of Rhizoctonia damping-off of radish and Rhizoctonia crown and root rot of poinsettia. Phytopathology 2001, 91, 1116–1123. [Google Scholar] [CrossRef] [PubMed]
- United Nations (UN). The 17 Goals. Department of Economic and Social Affairs. 2021. Available online: https://sdgs.un.org/goals (accessed on 8 February 2021).
Publisher’s Note: MDPI stays neutral with regard to jurisdictional claims in published maps and institutional affiliations. |
© 2021 by the authors. Licensee MDPI, Basel, Switzerland. This article is an open access article distributed under the terms and conditions of the Creative Commons Attribution (CC BY) license (https://creativecommons.org/licenses/by/4.0/).